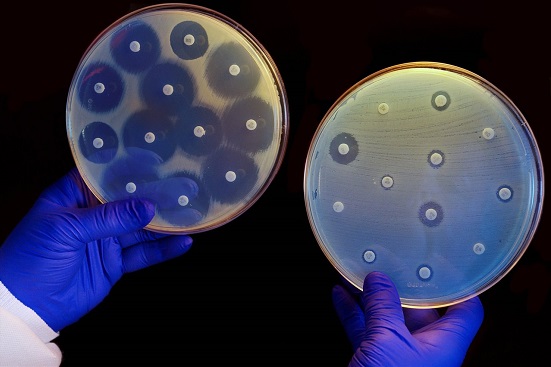

La resistencia a los antibióticos es una de las amenazas más serias para la salud mundial, como lo alerta la Organización Mundial de la Salud (OMS) en su informe sobre las bacterias que presentaron mayor resistencia ante los tratamientos.
Si pensabas que una simple infección tenía solución garantizada con una pastilla, es hora de repensarlo. La OMS revela cómo las bacterias están evolucionando más rápido de lo que la ciencia puede combatirlas, volviendo ineficaces a los tratamientos de uso habitual.
Este peligro no es futuro, es presente y global. Las bacterias, a las que podrías llamar «superbacterias», están causando que infecciones comunes se conviertan en padecimientos graves y potencialmente mortales.
¿Cuántas infecciones bacterianas son resistentes a los antibióticos?
Según el nuevo Informe mundial de la OMS sobre la vigilancia de la resistencia a los antibióticos 2025, los números de 2023 son preocupantes.
- En 2023, una de cada seis infecciones bacterianas confirmadas en laboratorio fue resistente a los tratamientos con antibióticos.
- Amenaza creciente a nivel global: El aumento de esta resistencia constituye una amenaza cada vez mayor para la salud mundial.
- Superando a la medicina moderna: La resistencia a los antimicrobianos avanza más rápido que los logros en la medicina actual, según la OMS.
- Riesgo de muerte por sepsis: Las infecciones bacterianas graves y resistentes frecuentemente terminan en una reacción que provoca una inflamación generalizada y daño en los tejidos y órganos (sepsis), fallo orgánico e incluso la muerte.
- Pocas opciones de tratamiento: La ineficacia creciente de antibióticos esenciales obliga a usar medicamentos de «último recurso», que son caros y difíciles de conseguir.
¿Cuánto aumentó la resistencia de las infecciones bacterianas?
El informe revela no solo el estado actual, sino también la velocidad con la que las bacterias ganan terreno en los últimos cinco años.
- Entre 2018 y 2023, la resistencia subió en más del 40% en las bacterias estudiadas.
- Incremento anual del 5% al 15%: El aumento promedio anual de la resistencia se situó entre el 5% y el 15%.
- Dependencia de la vigilancia: Es importante que los países fortalezcan la vigilancia para poder usar los antibióticos de manera responsable.
- Impacto en tratamientos esenciales: El aumento implica que antibióticos necesarios para tratar infecciones causadas por bacterias, como las fluoroquinolonas, son cada vez menos eficaces.
¿Cuáles son las bacterias más peligrosas y las regiones más afectadas?
Hay villanos claros en esta historia de salud, y ciertos lugares sufren más que otros el embate de la resistencia.
- Las bacterias gramnegativas son la mayor amenaza: Tienen una pared celular compleja con una membrana externa que las protege de algunos antibióticos, y son más peligrosas a nivel global.
- E. coli y K. pneumoniae lideran las infecciones graves: Estas son las principales bacterias halladas en las infecciones sanguíneas, las más graves. También provocan infecciones del tracto urinario, diarrea y neumonía.
- Alta resistencia a tratamientos de primera elección: Más del 40% de las infecciones por E. coli y el 55% por K. pneumoniae son resistentes a los tratamientos comunes.
- Asia Sudoriental y Mediterráneo Oriental, las más afectadas: Estas regiones registran la mayor resistencia, con una de cada tres infecciones notificadas siendo resistente.
- África también registra alta resistencia: Reporta que una de cada cinco infecciones analizadas era resistente.
El director general de la OMS, doctor Tedros Adhanom Ghebreyesus, insiste en que el futuro de la salud depende de la innovación en nuevos antibióticos y de que se fortalezcan los sistemas para prevenir, diagnosticar y tratar las infecciones.
En la lucha contra las superbacterias, el conocimiento y la responsabilidad son tus mejores armas. Por ello, nunca es aconsejable la automedicación.
Fuente: agencias